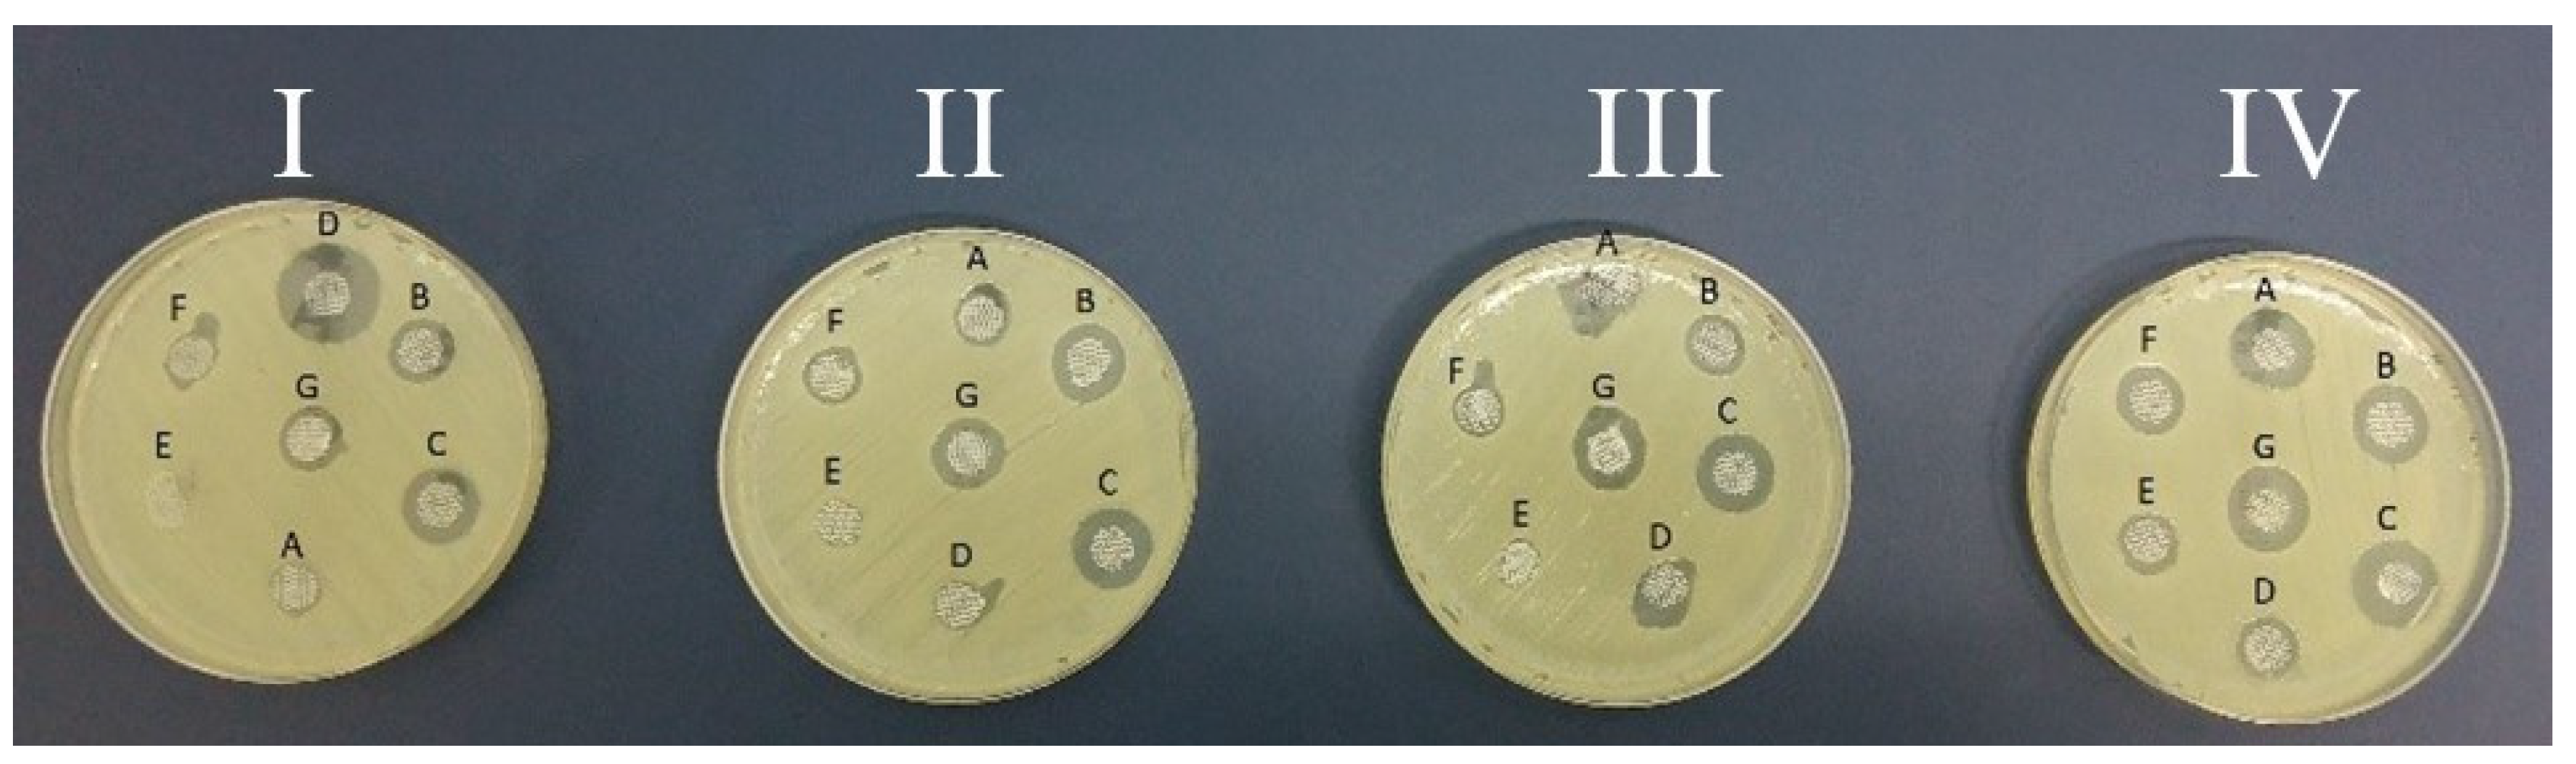
Medicina 60 01015 g002

Amnion as an Innovative Antiseptic Carrier: A Comparison of the Efficacy of Allogeneic and Xenogeneic Transplantations in the Context of Burn Therapy
Abstract
1. Introduction
2. Materials and Methods
2.1. The Reagents Used to Soak the Discs from the Human and Porcine Amniotic Membranes
- Control NaCl 0.9% solution;
- Prontosan (polyhexanide 0.1%, betaine 0.1%) (manufacturer: B Braun Melsungen AG, Melsungen, Germany);
- Braunol 7.5% (100 g of solution contains 7.5 g of povidone iodine—Povidonum iodinatum with a 10% iodine content) (manufacturer: B Braun Melsungen AG, Germany);
- Borasol 30 mg/g (1 g of skin solution contains 30 mg of boric acid) (manufacturer: PROLAB, Naklon/Notecią, Poland);
- Microdacyn (40 ppm hypochlorous acid (HOCl)) (manufacturer: Oculus Technologies of México S.A. de C. V., Zapopan, Jalisco, Mexico);
- Octenilin (Aqua valde purificata, Glycerol, Ethylhexylglycerin, Octenidine HCl) (manufacturer: Schülke&Mayr GmbH, Warsaw, Poland);
- Sutrisept (0.1% PHMB—polyhexanide; 1% Poloxamer 188) (manufacturer: ACTO GmbH, Warsaw, Poland).
2.2. The Collection and Preparation of the Amnion, Followed by Its Incubation in Antiseptics
2.3. Statistical Analysis
3. Results
4. Discussion
5. Conclusions
Author Contributions
Funding
Institutional Review Board Statement
Informed Consent Statement
Data Availability Statement
Conflicts of Interest
References
- Yang, H.; Li, Z.; Jin, W.; Yang, A. Application progress of human amniotic membrane in vitreoretinopathy: A literature review. Front. Med. 2023, 10, 1206577. [Google Scholar] [CrossRef] [PubMed] [PubMed Central]
- Kogan, S.; Sood, A.; Granick, M.S. Amniotic membrane adjuncts and clinical applications in wound healing: A review of the literature. Wounds 2018, 6, 168–173. [Google Scholar]
- Fénelon, M.; Catros, S.; Meyer, C.; Fricain, J.C.; Obert, L.; Auber, F.; Louvrier, A.; Gindraux, F. Applications of human amniotic membrane for tissue engineering. Membranes 2021, 11, 387. [Google Scholar] [CrossRef] [PubMed] [PubMed Central]
- Sabol, T.J.; Tran, G.S.; Matuszewski, J.; Weston, W.W. Standardized reporting of amnion and amnion/chorion allograft data for wound care. Health Sci. Rep. 2022, 5, 794. [Google Scholar] [CrossRef] [PubMed]
- Gholipourmalekabadi, M.; Farhadihosseinabadi, B.; Faraji, M.; Nourani, M.R. How do preparation and preservation procedures affect the properties of the amniotic membrane? How safe are these procedures? Burn. Inj. 2020, 46, 1254–1271. [Google Scholar] [CrossRef] [PubMed]
- Shanbhag, S.S.; Hall, L.; Chodosh, J.; Saeed, H.N. Long-term outcomes of amniotic membrane treatment in acute Stevens-Johnson syndrome/toxic epidermal necrolysis. Ocul. Surf. 2020, 18, 517–522. [Google Scholar] [CrossRef] [PubMed] [PubMed Central]
- Garoufalis, M.; Nagesh, D.; Sanchez, P.J.; Lenz, R.; Park, S.J.; Ruff, J.G.; Tien, A.; Goldsmith, J.; Seat, A. Use of dehydrated human amnion/chorion membrane allografts in more than 100 patients with six major types of refractory nonhealing wounds. J. Am. Podiatr. Med. Assoc. 2018, 108, 84–89. [Google Scholar] [CrossRef] [PubMed]
- Singh, N.; Phillips, M. Toxic Epidermal Necrolysis: A review of past and present therapeutic approaches. Skin Therapy Lett. 2022, 27, 7–13. [Google Scholar] [PubMed]
- Lee, E.Y.; Knox, C.; Phillips, E.J. Worldwide prevalence of antibiotic-associated stevens-johnson syndrome and toxic epidermal necrolysis: A systematic review and meta-analysis. JAMA Dermatol. 2023, 159, 384–392. [Google Scholar] [CrossRef] [PubMed] [PubMed Central]
- Rahman, M.S.; Islam, R.; Rana, M.M.; Spitzhorn, L.S.; Rahman, M.S.; Adjaye, J.; Asaduzzaman, S.M. Characterization of burn wound healing gel prepared from human amniotic membrane and Aloe vera extract. BMC Complement. Altern. Med. 2019, 19, 115. [Google Scholar] [CrossRef] [PubMed] [PubMed Central]
- Regulski, M. Utilization of a viable human amnion membrane allograft in elderly patients with chronic lower extremity wounds of various etiologies. Wounds 2018, 30, E36–E40. [Google Scholar] [PubMed]
- Oesman, I.; Hutami, W.D. Gamma-treated placental amniotic membrane allograft as the adjuvant treatment of unresponsive diabetic ulcer of the foot. Int. J. Surg. Case Rep. 2020, 66, 313–318. [Google Scholar] [CrossRef] [PubMed]
- Garcia, N.; Jiminez, V.; Graham, L.; Huang, C. Unique usages of dehydrated human amnion chorion membrane allografts in dermatology. J. Drugs Dermatol. 2023, 22, 1228–1231. [Google Scholar] [CrossRef] [PubMed]
- Klama-Baryła, A.; Kitala, D.; Łabuś, W.; Kraut, M.; Szapski, M.; Słomski, R. Is transgenic porcine skin as good as allogeneic skin for regenerative medicine? Comparison of chosen properties of Xeno- and allogeneic Material. Transplant. Proc. 2020, 52, 2208–2217. [Google Scholar] [CrossRef] [PubMed]
- Kitala, D.; Klama-Baryła, A.; Łabuś, W.; Kraut, M.; Glik, J.; Kawecki, M.; Joszko, K.; Gzik-Zroska, B. Porcine transgenic, acellular material as an alternative for human skin. Transplant. Proc. 2020, 52, 2218–2222. [Google Scholar] [CrossRef] [PubMed]
- Forbes, J.; Fetterolf, D.E. Dehydrated amniotic membrane allografts for the treatment of chronic wounds: A case series. J. Wound Care 2012, 21, 294–296. [Google Scholar] [CrossRef] [PubMed]
- Mohammadi, A.A.; Seyed Jafari, S.M.; Kiasat, M.; Tavakkolian, A.R.; Imani, M.T.; Ayaz, M.; Tolide-ie, H.R. Effect of fresh human amniotic membrane dressing on graft take in patients with chronic burn wounds compared with conventional methods. Burns 2013, 39, 349–353. [Google Scholar] [CrossRef] [PubMed]
- Leal-Marin, S.; Kern, T.; Hofmann, N.; Pogozhykh, O.; Framme, C.; Börgel, M.; Figueiredo, C.; Glasmacher, B.; Gryshkov, O. Human Amniotic Membrane: A review on tissue engineering, application, and storage. J. Biomed. Mater. Res. B Appl. Biomater. 2021, 109, 1198–1215. [Google Scholar] [CrossRef] [PubMed]
- Ramuta, T.Z.; Tratnjek, L.; Janev, A.; Seme, K.; Starcic Erjavec, M.; Kreft, M.E. The antibacterial activity of human amniotic membrane against multidrug-resistant bacteria associated with urinary tract infections: New insights from normal and cancerous urothelial models. Biomedicines 2021, 9, 218. [Google Scholar] [CrossRef] [PubMed] [PubMed Central]
- Moosazadeh Moghaddam, M.; Farhadie, B.; Mirnejad, R.; Kooshki, H. Evaluation of an antibacterial peptide-loaded amniotic membrane/silk fibroin electrospun nanofiber in wound healing. Int. Wound J. 2023, 20, 3443–3456. [Google Scholar] [CrossRef] [PubMed] [PubMed Central]
- Ramuta, T.Z.; Sket, T.; Starcic Erjavec, M.; Kreft, M.E. Antimicrobial activity of human fetal membranes: From biological function to clinical use. Front. Bioeng. Biotechnol. 2021, 9, 691522. [Google Scholar] [CrossRef] [PubMed] [PubMed Central]
- Wali, N.; Shabbir, A.; Wajid, N.; Abbas, N.; Naqvi, S.Z.H. Synergistic efficacy of colistin and silver nanoparticles impregnated human amniotic membrane in a burn wound infected rat model. Sci. Rep. 2022, 12, 6414. [Google Scholar] [CrossRef] [PubMed] [PubMed Central]
- Jhumi, I.J.; Arafat, T.A.; Karmakar, P.C.; Arifuzzaman, M.; Hossain, M.S.; Akhtar, N.; Asaduzzaman, S.M. Silver nanoparticle incorporated human amniotic membrane gel accelerates second-degree burn wound healing in wister rat. Evid. Based Complement. Alternat. Med. 2023, 2023, 9808556. [Google Scholar] [CrossRef] [PubMed] [PubMed Central]
- Li, Y.; An, S.; Deng, C.; Xiao, S. Human acellular amniotic membrane as skin substitute and biological scaffold: A review of its preparation, preclinical research, and clinical application. Pharmaceutics 2023, 15, 2249. [Google Scholar] [CrossRef] [PubMed] [PubMed Central]
- Ramasamy, P.; Krishnakumar, R.; Rekha, R.; Vaseeharan, B.; Saraswathi, K.; Raj, M.; Hanna, R.E.B.; Brennan, G.P.; Dayanithi, G.; Vijayakumar, S. Bio-fabrication of human amniotic membrane zinc oxide nanoparticles and the wet/dry ham dressing membrane for wound healing. Front. Bioeng. Biotechnol. 2021, 9, 695710. [Google Scholar] [CrossRef] [PubMed] [PubMed Central]
- Ashouri, S.; Hosseini, S.A.; Hoseini, S.J.; Tara, F.; Ebrahimzadeh-Bideskan, A.; Webster, T.J.; Kargozar, S. Decellularization of human amniotic membrane using detergent-free methods: Possibilities in tissue engineering. Tissue Cell 2022, 76, 101818. [Google Scholar] [CrossRef] [PubMed]
- Skopinska-Wisniewska, J.; Michalak, M.; Tworkiewicz, J.; Tyloch, D.; Tuszynska, M.; Bajek, A. Modification of the human amniotic membrane using different cross-linking agents as a promising tool for regenerative medicine. Materials 2023, 16, 6726. [Google Scholar] [CrossRef] [PubMed] [PubMed Central]
- Yüksel, S.; Aşık, M.D.; Aydin, H.M.; Tönük, E.; Aydın, E.Y.; Bozkurt, M. Fabrication of a multi-layered decellularized amniotic membranes as tissue engineering constructs. Tissue Cell 2022, 74, 101693. [Google Scholar] [CrossRef] [PubMed]
- Ramuta, T.Z.; Starcic Erjavec, M.; Kreft, M.E. Amniotic membrane preparation crucially affects its broad-spectrum activity against uropathogenic bacteria. Front. Microbiol. 2020, 11, 469. [Google Scholar] [CrossRef] [PubMed] [PubMed Central]
- Schmiedova, I.; Dembickaja, A.; Kiselakova, L.; Nowakova, B.; Slama, P. Using of amniotic membrane derivatives for the treatment of chronic wounds. Membranes 2021, 11, 941. [Google Scholar] [CrossRef] [PubMed] [PubMed Central]
- Farhadihosseinabadi, B.; Farahani, M.; Tayebi, T.; Jafari, A.; Biniazan, F.; Modaresifar, K.; Moravvej, H.; Bahrami, S.; Redl, H.; Tayebi, L.; et al. Amniotic membrane and its epithelial and mesenchymal stem cells as an appropriate source for skin tissue engineering and regenerative medicine. Artif. Cells Nanomed. Biotechnol. 2018, 46 (Suppl. 2), 431–440. [Google Scholar] [CrossRef] [PubMed]
- Bonomi, A.; Silini, A.; Vertua, E.; Signoroni, P.B.; Coccè, V.; Cavicchini, L.; Sisto, F.; Alessandri, G.; Pessina, A.; Parolini, O. Human amniotic mesenchymal stromal cells (hAMSCs) as potential vehicles for drug delivery in cancer therapy: An in vitro study. Stem Cell Res. Ther. 2015, 6, 155. [Google Scholar] [CrossRef] [PubMed]

| Antiseptic | A NaCl | B Prontosan | C Braunol | D Borasol | E Microdacyn | F Octenilin | G Sutrisept | |
|---|---|---|---|---|---|---|---|---|
| Strain | ||||||||
| Pseudomonas aeruginosa | 8 | 8 | 10 | 8 | 8 | 10 | 8 | |
| Acinetobacter baumannii | 8 | 12 | 14 | 18 | 8 | 8 | 10 | |
| Methicillin-sensitive Staphylococcus aureus (MSSA) | 8 | 14 | 19 | 8 | 8 | 12 | 17 | |
| Antiseptic | A NaCl | B Prontosan | C Braunol | D Borasol | E Microdacyn | F Octenilin | G Sutrisept | |
|---|---|---|---|---|---|---|---|---|
| Strain | ||||||||
| Pseudomonas aeruginosa | 8 | 10 | 10 | 8 | 8 | 10 | 10 | |
| Acinetobacter baumannii | 8 | 14 | 15 | 10 | 8 | 11 | 14 | |
| Methicillin-sensitive Staphylococcus aureus (MSSA) | 8 | 15 | 16 | 8 | 8 | 13 | 25 | |
| Antiseptic | A NaCl | B Prontosan | C Braunol | D Borasol | E Microdacyn | F Octenilin | G Sutrisept | |
|---|---|---|---|---|---|---|---|---|
| Strain | ||||||||
| Pseudomonas aeruginosa | 8 | 9 | 10 | 8 | 8 | 10 | 10 | |
| Acinetobacter baumannii | 8 | 11 | 15 | 10 | 10 | 10 | 14 | |
| Methicillin-sensitive Staphylococcus aureus (MSSA) | 8 | 15 | 20 | 17 | 8 | 15 | 20 | |
| Antiseptic | A NaCl | B Prontosan | C Braunol | D Borasol | E Microdacyn | F Octenilin | G Sutrisept | |
|---|---|---|---|---|---|---|---|---|
| Strain | ||||||||
| Pseudomonas aeruginosa | 8 | 9 | 12 | 8 | 8 | 11 | 9 | |
| Acinetobacter baumannii | 12 | 15 | 16 | 15 | 12 | 13 | 15 | |
| Methicillin-sensitive Staphylococcus aureus (MSSA) | 14 | 15 | 20 | 14 | 15 | 15 | 25 | |
Disclaimer/Publisher’s Note: The statements, opinions and data contained in all publications are solely those of the individual author(s) and contributor(s) and not of MDPI and/or the editor(s). MDPI and/or the editor(s) disclaim responsibility for any injury to people or property resulting from any ideas, methods, instructions or products referred to in the content. |
© 2024 by the authors. Licensee MDPI, Basel, Switzerland. This article is an open access article distributed under the terms and conditions of the Creative Commons Attribution (CC BY) license (https://creativecommons.org/licenses/by/4.0/).
Share and Cite
Klama-Baryła, A.; Sitkowska, A.; Łabuś, W.; Strzelec, P.; Kraut, M.; Smętek, W.; Śliwiński, W.; Maciejowski, R.; Gierek, M. Amnion as an Innovative Antiseptic Carrier: A Comparison of the Efficacy of Allogeneic and Xenogeneic Transplantations in the Context of Burn Therapy. Medicina 2024, 60, 1015. https://doi.org/10.3390/medicina60061015
Klama-Baryła A, Sitkowska A, Łabuś W, Strzelec P, Kraut M, Smętek W, Śliwiński W, Maciejowski R, Gierek M. Amnion as an Innovative Antiseptic Carrier: A Comparison of the Efficacy of Allogeneic and Xenogeneic Transplantations in the Context of Burn Therapy. Medicina. 2024; 60(6):1015. https://doi.org/10.3390/medicina60061015
Chicago/Turabian StyleKlama-Baryła, Agnieszka, Anna Sitkowska, Wojciech Łabuś, Przemysław Strzelec, Małgorzata Kraut, Wojciech Smętek, Wojciech Śliwiński, Ryszard Maciejowski, and Marcin Gierek. 2024. "Amnion as an Innovative Antiseptic Carrier: A Comparison of the Efficacy of Allogeneic and Xenogeneic Transplantations in the Context of Burn Therapy" Medicina 60, no. 6: 1015. https://doi.org/10.3390/medicina60061015
APA StyleKlama-Baryła, A., Sitkowska, A., Łabuś, W., Strzelec, P., Kraut, M., Smętek, W., Śliwiński, W., Maciejowski, R., & Gierek, M. (2024). Amnion as an Innovative Antiseptic Carrier: A Comparison of the Efficacy of Allogeneic and Xenogeneic Transplantations in the Context of Burn Therapy. Medicina, 60(6), 1015. https://doi.org/10.3390/medicina60061015

